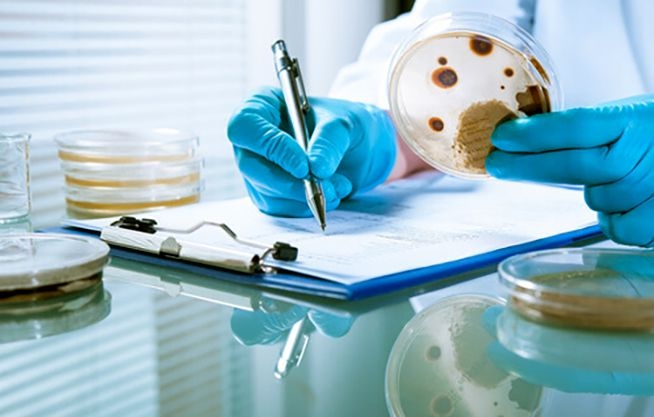

- Laboratorio de Química de los Alimentos
- Laboratorio de Biología Molecular
- Laboratorio de Genómica y Biología Integrativa
- Laboratorio de Genómica y Bioinformática para la Biodiversidad
- Laboratorio de Genética Humana
- Laboratorio de Biología Celular
- Laboratorio de Biología Acuática y Acuicultura
- Laboratorio de Bioquímica
- Laboratorio de Citogenética y Bioensayos
- Laboratorio de Citogenética "Misael Guevara Paredes"
- Laboratorio de Genética
- Laboratorio de Bioquímica de Toxinas Naturales
- Laboratorio de Recursos Genéticos y Biotecnología
- Laboratorio de Radiobiología
Laboratorio de Química de los Alimentos
Cuenta con equipos que posibilitan la investigación del análisis bioquímico de la composición de alimentos a nivel molecular al que se incluirá a los recursos naturales, complementando con análisis bioinformático a nivel molecular y la participación de los profesores miembros.
En el laboratorio se analiza la composición química de alimentos con énfasis en análisis proximal que corresponde a la determinación porcentual de contenido de humedad, proteína total, grasa total, carbohidratos y cenizas. También se realizan análisis sobre determinación de acidez en leche, caracterización de almidones de tubérculos y raíces utilizando ensayos de retrogradación y gelatinización que, complementados con otros análisis físico-químicos, hace posible conocer su potencialidad para uso en la industria.
Responsable: Mag. Vidalina Irene Heredia Jimenez
Miembros: Daniel Saúl Oré Chávez, Blgo. Jorge Zeballos Alva

Celular: 902329771
E-mail: vherediaj@unmsm.edu.pe
Laboratorio de Biología Molecular
El Laboratorio de Biología Molecular está dedicado a la investigación de venenos de origen animal desde hace 35 años. Los estudios que se realizan abarcan la identificación, caracterización bioquímica y biológica, así como el análisis de secuencias nucleotídicas y principios activos presentes en venenos de serpientes, arañas y otras especies.
Las investigaciones se han centrado en tres áreas fundamentales: en la primera, se han caracterizado varias enzimas del veneno de serpientes especialmente Lachesis muta, Bothrops atrox, Bothrops barnetti, Bothrops pictus y Bothrops brazili; entre estos componentes están las enzimas similares a trombina, fosfolipasa A2, proteasas hemorrágicas y no hemorrágicas, L-aminoácido oxidasas y factores de difusión. En el caso de las arañas, se han identificado proteínas con acción hemorrágica, alergénica y hemolítica. En la segunda área, se han realizado estudios sobre sueros o antivenenos contra serpientes y arañas, y recientemente se ha desarrollado un procedimiento para preparar antivenenos en gallinas y los anticuerpos tipo IgY son recuperados y analizados a partir de las yemas de sus huevos. En la tercera área, se están efectuando estudios moleculares con venenos de serpientes, arañas y escorpiones, habiéndose logrado establecer secuencias génicas de varios principios activos; de ellos, las secuencias génicas de la enzima similar a trombina de Bothrops barnetti está depositada en el GenBank.
Para estos estudios, nuestro laboratorio cuenta con importantes socios científicos: la Universidad Federal de Minas Gerais, Brasil (estudios sobre escorpiones y arañas), la Fundación Ezequiel Dias, Brasil (Proteómica de venenos), el Instituto Clodomiro Picado, Costa Rica, el Instituto Nacional de Salud, Lima, Perú (análisis de antivenenos), y el Instituto Clemente Estable, Uruguay (estudios genómicos).
Responsable: Dr. Armando Yarlequé Chocas
Miembros: Fanny Lazo Manrique, Edith Rodríguez Quispe, Dan Vivas Ruíz, Gustavo Sandoval Peña

Celular: (+51) 619 7000 anexo 1528
E-mail: ayarlequec@unmsm.edu.pe
Laboratorio de Genómica y Biología Integrativa
Responsable: Dra. Mónica Yolanda Paredes Anaya

Laboratorio de Genómica y Bioinformática para la Biodiversidad
El Laboratorio de Genómica y Bioinformática para la Biodiversidad (FCB-UNMSM) tiene un interés general en el uso de herramientas bioinformáticas y genómicas para el estudio y conservación de la biodiversidad. Nuestro principal enfoque es entender los mecanismos moleculares que moldean la diversidad y adaptación de microorganismos, plantas y animales silvestres. También tenemos un fuerte interés en la aplicación de estas herramientas para responder preguntas básicas y aplicadas.
Actualmente estamos llevando a cabo investigaciones que involucran genómica, transcriptómica y metabarcoding del algarrobo; y metabarcoding para la identificación de especies por código de barras.
Responsable: Dra. María Gisella Orjeda Fernández

Laboratorio de Genética Humana
En el Laboratorio se realizan 3 tipos de actividades académicas: a) Investigación en las áreas de la Genética Molecular Humana y Citogenética Humana; b) Docencia, la infraestructura y el equipamiento del Laboratorio sustentan las prácticas de los cursos de Genética Humana y Citogenética Humana que se dictan para la EAP de Genética y Biotecnología y c) Servicio Académico Asistencial de Genética Humana.
Se desarrollan proyectos de investigación en el área de la Genética Molecular Humana que tienen como objetivos generales caracterizar las variables moleculares de los genes nucleares MBL2 y ACE en algunas etnias peruanas, tendientes a establecer no solo las frecuencias poblacionales sino también las relaciones filogenéticas que brinden información acerca de la génesis y las rutas migratorias de las poblaciones peruanas.
Responsable: Mg. Claudia Fiorella Barletta Carrillo

Laboratorio de Biología Celular
El Laboratorio de Biología Celular desarrolla investigaciones acerca de la actividad biológica de metabolitos secundarios provenientes de animales y plantas en la proliferación celular.
Estamos evaluando la actividad antitumoral de metabolitos secundarios provenientes de invertebrados marinos, con la finalidad de obtener nuevas moléculas con potencial antitumoral e interactuar con la industria farmacéutica. Además evaluamos la actividad de toxinas provenientes de himenópteros con la finalidad de aislar el o los componentes que causan alergias. De otro lado, estamos incursionando en la actividad de sustancias químicas que puedan actuar en células del sistema nervioso para solucionar problemas como el Alzheimer.
Responsable: Mg. Fernando Octavio Retuerto Prieto

Laboratorio de Biología Acuática y Acuicultura
Las investigaciones son realizadas en peces y crustáceos de ambiente continental y marino y están enfocadas al manejo de sistemas de cultivo controlado para entender la biología, fisiología metabólica, la reproducción y el manejo alimentario de diversas especies. En el LABAA también se realizan investigaciones con evaluación de sustancias e insumos diversos mediante bioensayos en condiciones controladas y actualmente se está implementándose la investigación en genética molecular.
Responsable: Mg. Guillermo Odilón Alvarez Bejar

Laboratorio de Bioquímica
La investigación del laboratorio gira en torno a la caracterización bioquímica y molecular de la respuesta de invertebrados acuáticos y peces, para la identificación de mecanismos de adaptación frente a variaciones abióticas, como efectos de la temperatura, efectividad de condiciones de cultivo, capacidad de recuperación frente a dosis subletales de compuestos tóxicos, efectividad de alimento, entre otros. Se viene realizando el análisis de marcadores moleculares para la identificación de especies, aislamiento y análisis de marcadores de estrés (malondialdehido, superóxido dismutasa, lactato deshidrogenasa, entre otros), así como el análisis del índice ARN/ADN y de proteínas totales para la determinación del estado nutricional de los organismos. Se investiga además, el aislamiento y caracterización de toxinas producidas o almacenadas por invertebrados que afectan a organismos superiores y la elaboración de instrumentos para su detección a nivel molecular.
Responsable: Mg. Patricia Gloria Woll Toso

Laboratorio de Citogenética y Bioensayos
Responsable: Blga. Rosa Antonia Gonzáles Gonzáles

Celular: (+51) 619 7000 anexo 1526
E-mail: rgonzalesg@unmsm.edu.pe
Laboratorio de Citogenética "Misael Guevara Paredes"
El laboratorio de Citogenética realiza trabajos de investigación, relacionados con esta disciplina, que están orientados a proporcionar una variable más para caracterizar la biodiversidad de nuestro ecosistema. Hemos realizado la caracterización citogenética en animales (Rhynchosciara americana, Telmatoscopus albipunctatus y algunas especies del Género Bostryxs), en plantas (Capsicum pubescens, Tropaeolum majus, Phaseolues vulgaris entre otras). También hemos utilizado técnicas citogenéticas para evaluar los efectos citotóxicos de efluentes de curtiembres, usando el test de Allium cepa.
Contamos con un cepario de Drosophila melanogaster, y estamos comenzando investigaciones a nivel genético en colaboración con el biofísico David A. Laván Quiroz, M.Sc. and Ph.D del Research Program in Aerospace de Sciences Division, NASA Ames Research Center, el laboratorio de Biología Molecular del Instituto Peruano de Energía Nuclear (IPEN) y con el Instituto Nacional de Investigación y Capacitación de Telecomunicaciones de la Universidad Nacional de Ingeniería (INICTEL-UNI). Estos estudios están dirigidos principalmente a encontrar los efectos nocivos del RFID (Identificación de radiofrecuencia) en el desarrollo de Drosophila melanogaster. Con los resultados de este trabajo queremos dejar abierta la posibilidad de poder extrapolar en mamíferos, sobretodo en neonatos, con la finalidad de garantizar el uso de RFID como equipo de ayuda hospitalaria. Siguiendo en esta línea de trabajo estamos haciendo estudios preliminares que tienen como objetivo encontrar probables sensores genéticos en Drosophila melanogaster que detecten campo magnético.
Responsable: Mg. Alberto Ernesto López Sotomayor

Laboratorio de Genética
La investigación en el laboratorio se centra principalmente en realizar estudios de diversidad genética a nivel cromosómico, molecular, morfológico y fenotípico con énfasis en recursos nativos. El laboratorio desarrolla proyectos que contribuyen a la caracterización de especies de interés nacional y su revalorización. Adicionalmente, tiene como área de interés el acceso a recursos biológicos y genéticos (animales y vegetales) con fines de investigación y docencia, así como los aspectos bioéticos relacionados con la genética en particular y las ciencias biológicas en general.
Nuestro interés abarca también entablar contacto con asociaciones y/o comunidades dedicadas a la conservación y manejo de los recursos genéticos con miras a la caracterización del germoplasma y asesoramiento en el sistema ABS y el reparto equitativo de beneficios, estableciendo redes de cooperación.
Responsable: Mg. Alberto Ernesto López Sotomayor

Laboratorio de Bioquímica de Toxinas Naturales
En el laboratorio se realizan investigaciones sobre la composición y acción bioquímica de venenos de escorpiones correspondientes a especies de nuestro país. En particular se estudian aquellas toxinas del veneno con acción sobre el sistema nervioso de mamíferos e insectos, así como péptidos con acción antibacteriana. Adicionalmente se estudian algunas enzimas presentes en estos venenos, como fosfolipasa, proteasa e hialuronidasa.
Algunos de estos principios activos, como por ejemplo las insectotoxinas y los péptidos antibacterianos, tienen especial importancia por el potencial uso que podrían tener en el control biológico de plagas y en el tratamiento de enfermedades producidas por bacterias patógenas, respectivamente.
Entre las especies de escorpiones cuyos venenos se vienen estudiando, tenemos a Hadruroides lunatus, H. bustamantei, H. charcasus, Brachistosternus ehrenberghii, Centruroides margaritatus y Tityus footei.
Responsable: Mg. Carmen Amelia Pantigoso Flores
Laboratorio de Recursos Genéticos y Biotecnología
Nuestra investigación está dirigida a la conservación, manejo y aprovechamiento (fitomejoramiento y producción de semilla) de los recursos genéticos vegetales. Se aplican técnicas in vitro para conservación, regeneración (organogénesis y embriogénesis), micropropagación, así como técnicas bioquímicas y moleculares para estudios de caracterización y genómica. Nuestro programa incluye investigaciones tanto en raíces y tubérculos andinos, como en plantas ornamentales y frutales.
Estamos interesados en desarrollar programas de producción e investigación participativa, que incluyan raíces y tubérculos andinos, plantas ornamentales y frutales u otras especies de plantas (por ejemplo, forestales e industriales). Ofrecemos servicios de producción de semilla y asesorías a productores, como industriales y centros de investigación tecnológica y/o académica. Realizamos servicios de consultoría en gestión de la investigación y la propiedad intelectual, estudios de impacto ambiental asociados a los Organismos vivos modificados, biotecnología, bioética y bioseguridad.
Responsable: Blgo. Rolando Estrada Jiménez

Celular: (+51) 619 7000 anexo 1557
E-mail: restradaj@unmsm.edu.pe
Laboratorio de Radiobiología
El laboratorio de Radiobiología se encuentra en proceso de formación y organización, la responsable participa como miembro de la Red Latinoamericana de Dosimetría Biológica (LBDNET), las actividades de la red incluyen reuniones técnicas para la armonización de protocolos, unificación de los criterios de recuento de aberraciones cromosómicas inestables, discusión de métodos estadísticos y programas para el cálculo de dosis y ejercicios de intercomparación. Las actividades de la red también incluyen investigaciones de implementación de nuevas tecnologías biodosimétricas para responder a emergencias de la región.
El laboratorio de Radiobiología es el lugar físico para la estandarización de prácticas y preparación de clases de los cursos de Antropología Biológica y Radiobiología.

